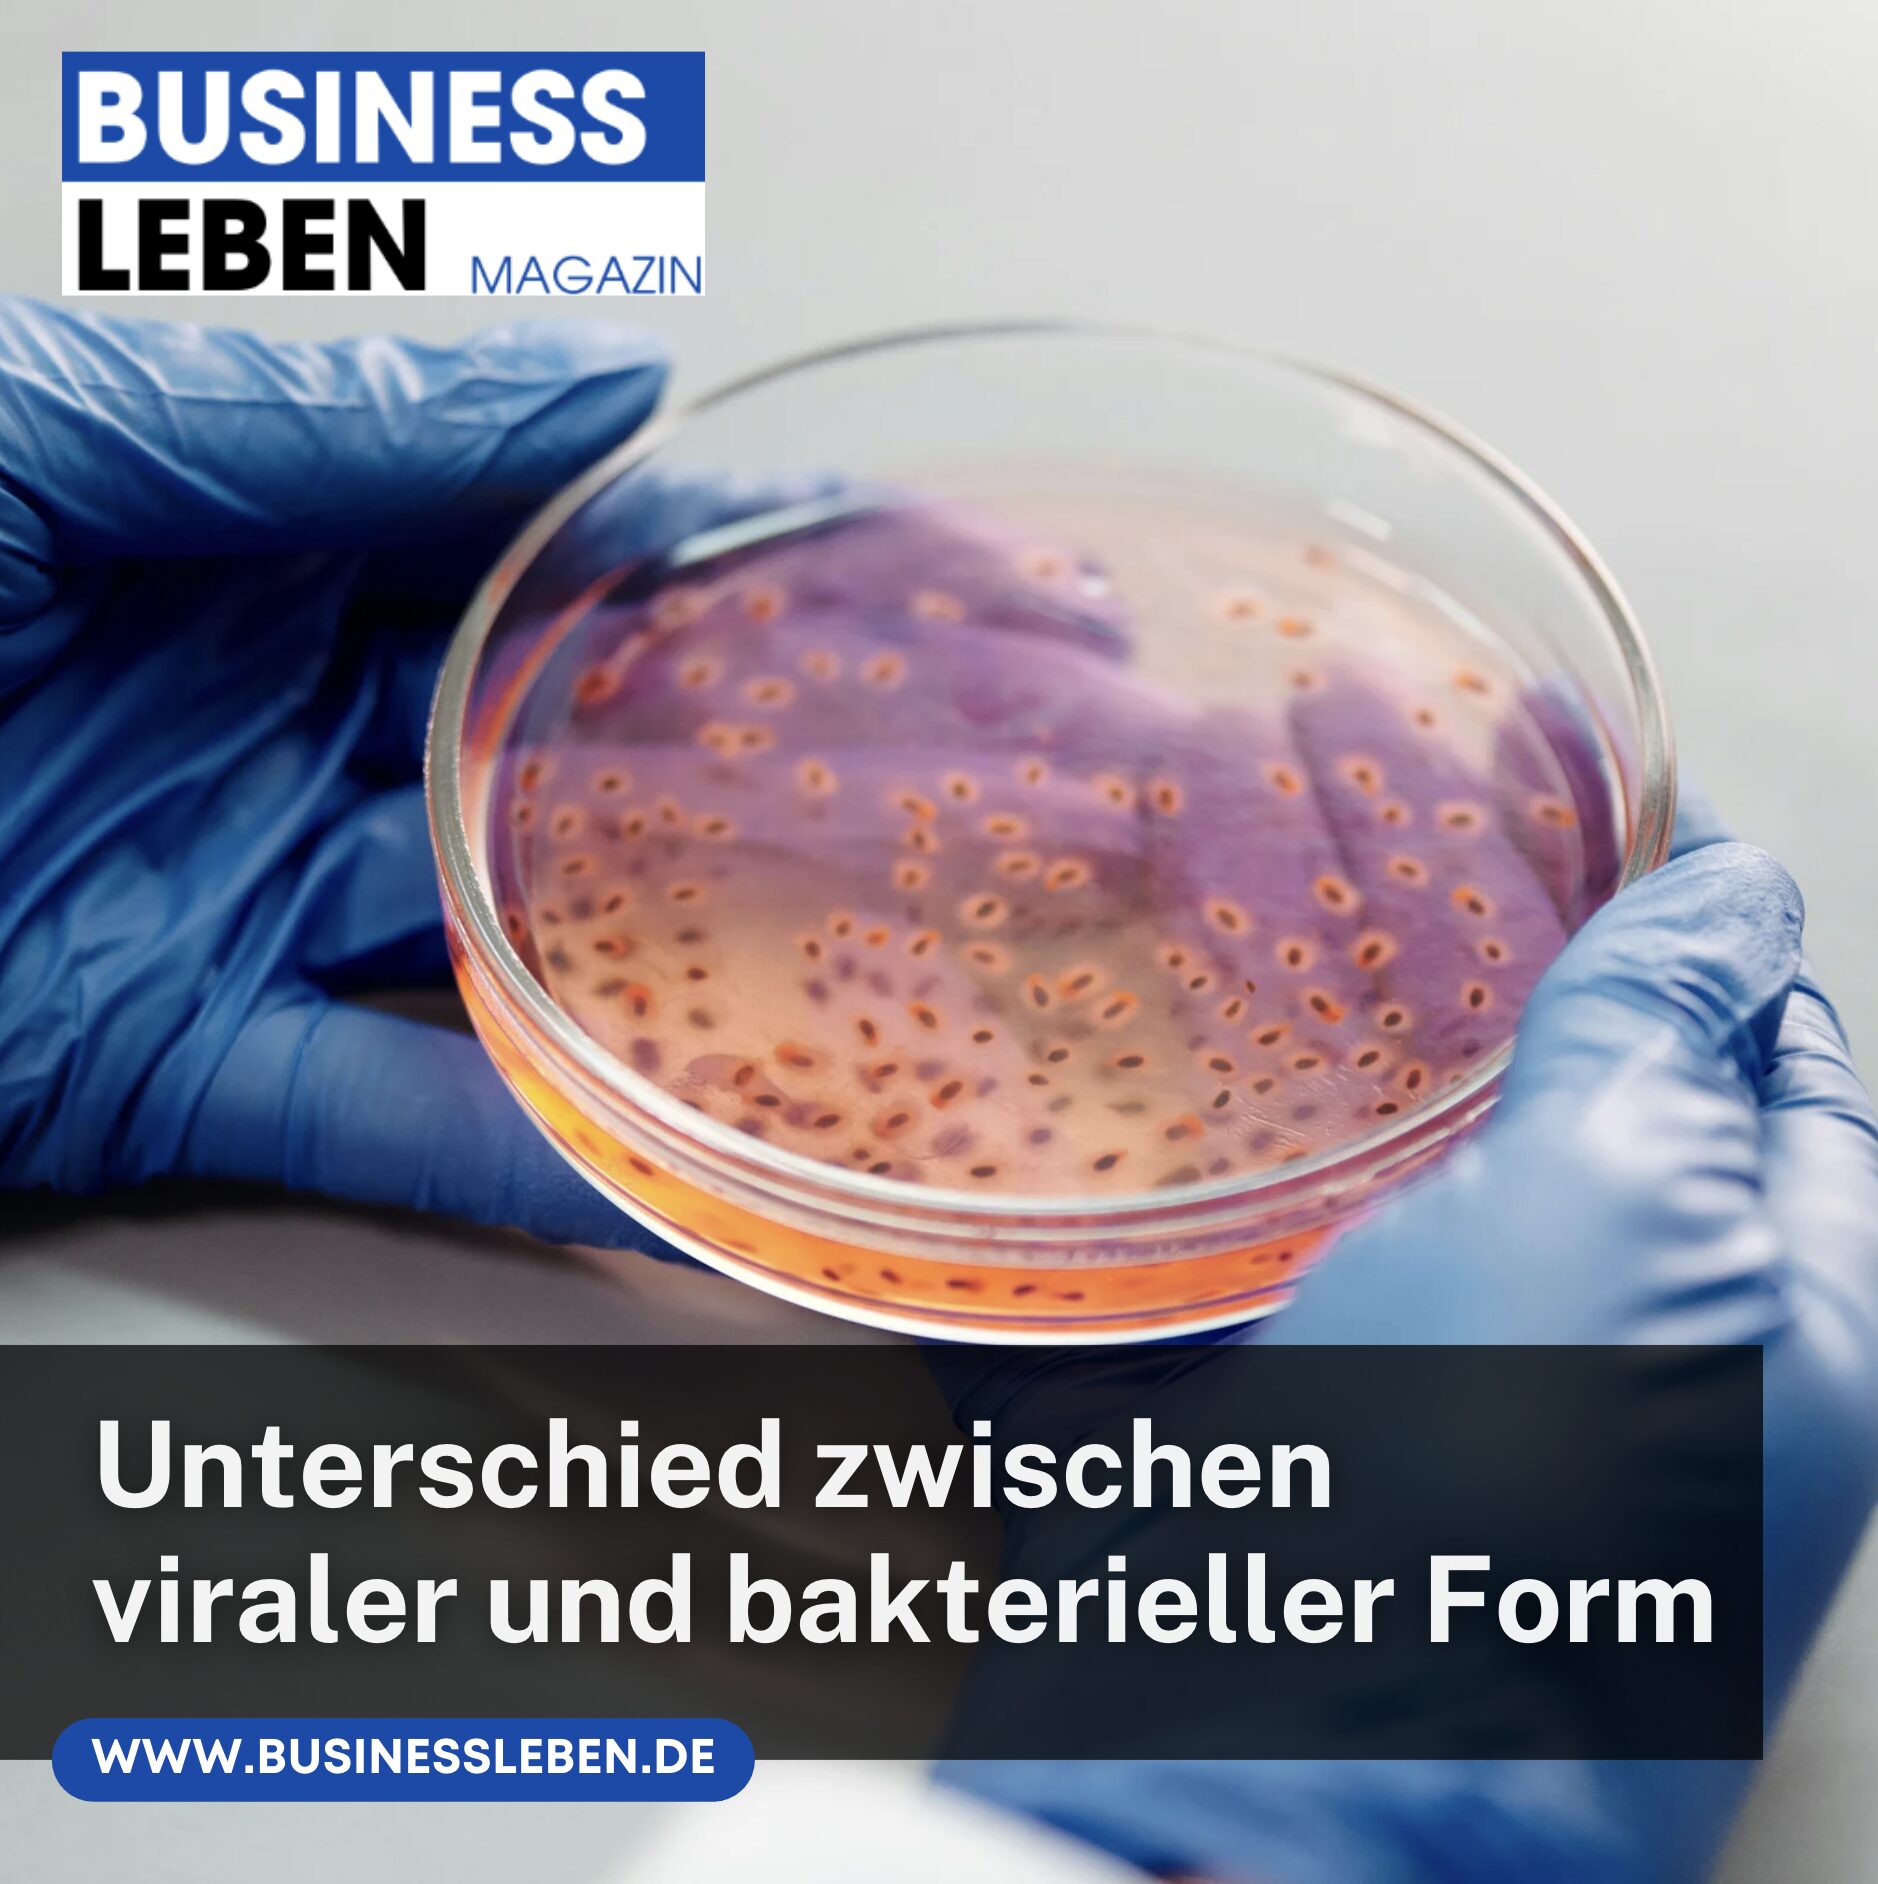

Mit Bindehautentzündung arbeiten zu gehen ist für viele Betroffene eine schwierige Entscheidung. Schon am ersten Tag der Beschwerden stellt sich die Frage, ob die Symptome mild genug sind, um den Arbeitsalltag zu bewältigen, oder ob es besser ist, sich zu schonen.
In diesem Artikel erhältst du umfassende Informationen zu Ursachen, Symptomen, Ansteckungsrisiken und Behandlungsoptionen, um eine fundierte Entscheidung treffen zu können. So kannst du einschätzen, wann der Gang zur Arbeit vertretbar ist und wann eine Pause notwendig wird.
Warum mit Bindehautentzündung arbeiten problematisch sein kann
Mit Bindehautentzündung arbeiten zu gehen kann sowohl für dich selbst als auch für andere ein Risiko darstellen. Eine infektiöse Form ist oft hoch ansteckend und breitet sich leicht aus. Die Belastung für das Auge durch Bildschirmarbeit oder staubige Umgebungen kann die Heilung zusätzlich verzögern.
Besonders bei einer bakteriellen oder viralen Konjunktivitis ist die Gefahr groß, Kollegen anzustecken. Häufig reichen schon kurze Kontakte oder gemeinsam genutzte Gegenstände wie Tastaturen oder Telefone, um Erreger zu übertragen.
Zudem führt die Erkrankung oft zu Rötung, Juckreiz, Brennen und vermehrtem Tränenfluss, was die Konzentration und Leistungsfähigkeit beeinträchtigen kann. Daher ist es sinnvoll, die Symptome ernst zu nehmen und im Zweifel ärztlichen Rat einzuholen.
Häufige Symptome einer Bindehautentzündung
Eine Bindehautentzündung zeigt sich in den meisten Fällen durch ein rotes Auge, oft begleitet von einem Fremdkörpergefühl. Hinzu kommen Juckreiz, Brennen oder Lichtempfindlichkeit.
Häufig tritt ein wässriges oder eitriges Sekret auf, das vor allem morgens zu verklebten Lidern führt. Bei einer bakteriellen Infektion ist das Sekret meist gelblich oder grünlich, während eine virale Form eher wässrig ist.
Manchmal sind beide Augen betroffen. Die Augenlider können geschwollen sein und es kann zu einer Schwellung der Lymphknoten vor dem Ohr kommen. In schweren Fällen sollte unbedingt ein Augenarzt aufgesucht werden.
Unterschied zwischen viraler und bakterieller Form
Eine bakterielle Bindehautentzündung wird durch Bakterien verursacht und spricht gut auf antibiotische Augentropfen oder Salben an. Diese Form ist oft von einem gelblich-grünen Sekret begleitet.
Die virale Konjunktivitis, häufig ausgelöst durch Adenoviren, ist besonders ansteckend und kann deutlich länger dauern. Hier helfen Antibiotika nicht, da sie nur gegen Bakterien wirken.
Beide Formen können sehr unangenehm sein und erfordern unterschiedliche Behandlungsansätze. Der Arzt entscheidet in der Regel anhand von Symptomen und Untersuchungen, welche Therapie geeignet ist.
Ursachen und Risikofaktoren
Die Ursachen für eine Bindehautentzündung sind vielfältig. Neben Bakterien und Viren spielen auch allergische Reaktionen oder mechanische Reizungen eine Rolle.
Eine allergische Bindehautentzündung tritt häufig bei Pollenflug oder Kontakt mit Tierhaaren auf. Diese Form ist nicht ansteckend, kann jedoch sehr störend sein.
Infektiöse Formen werden oft durch direkten Kontakt mit Sekreten übertragen. Gemeinsame Handtücher oder Waschlappen erhöhen das Risiko. Auch in Schwimmbädern kann es zu einer Übertragung kommen.
Ansteckungsgefahr im Arbeitsumfeld
Wer mit Bindehautentzündung arbeiten möchte, sollte wissen, dass die Ansteckungsgefahr bei infektiösen Formen sehr hoch ist. Besonders in Büros, Schulen, Kindergärten oder im Gesundheitswesen kann sich die Erkrankung rasch verbreiten.
Hygienemaßnahmen wie regelmäßiges Händewaschen, das Meiden von engem Körperkontakt und die Vermeidung gemeinsamer Textilien sind entscheidend.
Trotz aller Vorsicht bleibt das Risiko bestehen, andere zu infizieren. Deshalb raten Ärzte bei einer nachgewiesenen infektiösen Bindehautentzündung in der Regel zur Krankschreibung.
Mit Bindehautentzündung arbeiten: Dauer und Verlauf
Die Dauer einer Bindehautentzündung hängt stark von der Ursache ab. Eine bakterielle Form heilt mit entsprechender Behandlung oft innerhalb weniger Tage.
Eine virale Bindehautentzündung kann dagegen bis zu zwei Wochen oder länger anhalten. In seltenen Fällen treten Komplikationen auf, etwa wenn die Hornhaut mitbetroffen ist.
Der Verlauf lässt sich durch Schonung, gute Hygiene und gezielte Therapie positiv beeinflussen. Wer zu früh wieder arbeitet, riskiert eine längere Krankheitsphase.
Behandlungsmöglichkeiten der Bindehautentzündung
Die Behandlung richtet sich nach der Ursache. Bei einer bakteriellen Infektion verschreibt der Arzt meist antibiotische Augentropfen oder Salben.
Bei einer viralen Form steht die Linderung der Beschwerden im Vordergrund. Kühle Kompressen, künstliche Tränen und eine saubere Lidpflege können helfen. Kortikosteroidhaltige Augentropfen kommen nur in speziellen Fällen zum Einsatz.
Bei einer allergischen Bindehautentzündung helfen antiallergische Präparate und das Meiden des Allergieauslösers.
Wann man zu Hause bleiben sollte
Wer unter starken Symptomen leidet, sollte nicht mit Bindehautentzündung arbeiten gehen. Besonders bei Eiterbildung, starker Rötung oder Lichtempfindlichkeit ist eine Auszeit sinnvoll.
Auch wenn die Erkrankung hochansteckend ist, hat die Rücksicht auf Kollegen und Kunden Vorrang.
Eine Krankschreibung ist oft die beste Lösung, um die Genesung zu fördern und eine Ausbreitung der Krankheit zu verhindern.
Wann ein Arztbesuch notwendig ist
Ein Arzt sollte aufgesucht werden, wenn die Beschwerden stark sind, länger anhalten oder mit Sehstörungen einhergehen.
Auch Schmerzen, Schwellungen oder eine Verschlechterung trotz Behandlung sind Warnsignale.
Der Augenarzt kann feststellen, ob Bakterien oder Viren die Ursache sind und die passende Therapie verordnen.
Hygienetipps zur Vorbeugung
Regelmäßiges Händewaschen, das Nutzen eigener Handtücher und das Vermeiden von Augenreiben sind die wichtigsten Maßnahmen.
Oft verklebte Lider lassen sich vorsichtig mit warmem Wasser reinigen. Benutzte Tücher sollten danach sofort gewaschen werden.
Diese Tipps sind nicht nur während der Erkrankung, sondern auch im Alltag hilfreich, um das Risiko einer Ansteckung zu senken.
Fazit: Mit Bindehautentzündung arbeiten
Mit Bindehautentzündung arbeiten zu gehen, ist nur in seltenen Fällen ratsam. Die Erkrankung ist oft ansteckend, belastet das Auge und kann die Heilung verzögern.
Wer auf ärztliche Empfehlungen hört, Hygienemaßnahmen beachtet und sich bei Bedarf schont, schützt nicht nur sich selbst, sondern auch sein Umfeld.
FAQs: Mit Bindehautentzündung arbeiten – Wir antworten auf Ihre Fragen
Wie lange muss man zu Hause bleiben bei einer Bindehautentzündung?
| Art der Bindehautentzündung | Empfohlene Dauer zu Hause | Anmerkungen |
|---|---|---|
| Virale Bindehautentzündung | 1–2 Wochen | Sehr ansteckend, während dieser Zeit zu Hause bleiben, um eine Ausbreitung zu verhindern |
| Bakterielle Bindehautentzündung | 3–5 Tage | Symptome klingen oft schnell ab, wenn Antibiotika eingesetzt werden; trotzdem zu Hause bleiben, um andere nicht anzustecken |
| Allergische Bindehautentzündung | Keine feste Dauer | Nicht ansteckend; bei milden Symptomen kann gearbeitet werden, bei stärkeren Beschwerden ist Erholung ratsam |
Tipp: Bei starkem Brennen, vermehrtem Ausfluss oder Schwellungen lieber zu Hause bleiben, bis die Symptome deutlich abklingen.
Darf man mit einer Bindehautentzündung in der Kita arbeiten?
Ob Sie mit einer Bindehautentzündung in der Kita arbeiten dürfen, hängt von mehreren Faktoren ab:
- Bakterielle oder virale Bindehautentzündung: Hier sollten Sie zu Hause bleiben, da die Entzündung sehr ansteckend ist und Kinder leicht infizieren können.
- Allergische Bindehautentzündung: Diese ist nicht ansteckend, sodass Sie ohne Bedenken arbeiten können, wenn die Symptome mild sind.
Was sollte man mit einer Bindehautentzündung nicht machen?
Es gibt einige Dinge, die Sie während einer Bindehautentzündung unbedingt vermeiden sollten, um die Heilung zu fördern und eine Ansteckung zu verhindern:
- Nicht am Auge reiben: Reiben kann die Entzündung verschlimmern und die Infektion verbreiten.
- Vermeiden Sie Kontaktlinsen: Wenn Sie Kontaktlinsen tragen, sollten Sie diese während einer Bindehautentzündung nicht benutzen, um die Heilung zu unterstützen und eine weitere Reizung zu verhindern.
- Kein Schwimmen im Pool: Chlorwasser kann die Entzündung verschlimmern und eine weitere Reizung verursachen.
- Kein Teilen von Handtüchern oder Kosmetik: Um eine Ansteckung anderer zu vermeiden, verwenden Sie nur persönliche Hygieneartikel.